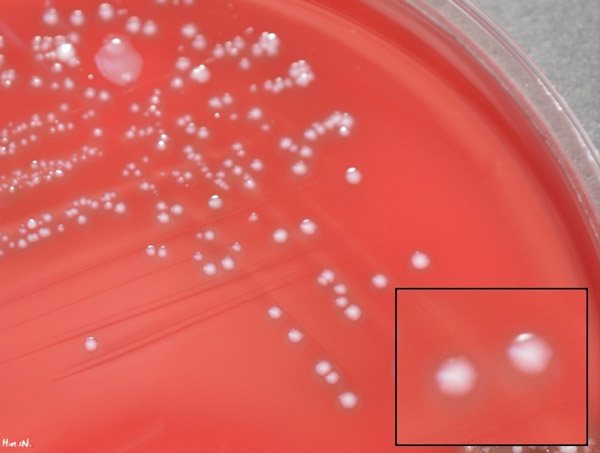

Микрофлора женского влагалища состоит более чем из 100 видов разнообразных бактерий и микроорганизмов. Присутствие полезных и патогенных клеток обусловливается тем, что подобным образом организм пытается выработать иммунитет.
Благодаря иммунной системе полезные микроорганизмы контролируют патогенную флору, понижая численность вредных микроорганизмов. Механизм защиты женского влагалища и внутренних половых органов работает самостоятельно. Для поддержания его функционирования не нужно принимать дополнительные препараты, пользоваться свечами и т.д. Залог здоровой микрофлоры – это ведение здорового образа жизни и соблюдение правил гигиены.
Что такое стрептококк агалактия
Группа условно-патогенных бактерий, называемая стрептококками, в небольших концентрациях может присутствовать в организме человека, не вызывая развития инфекции или воспаления. Все микроорганизмы рода Streptococcus по характеру роста на питательных средах подразделяют на гемолитические, негемолитические и зеленящие. Стрептококки из рода агалактия (Streptococcus agalactiae) относятся к грамположительным бета-гемолитическим стрептококкам группы В.
Бактерия попадает в организм после начала половой жизни, обитает во влагалище, прямой кишке, урогенитальном тракте и носоглотке. Существует риск заражения ребенка от инфицированной матери во время родоразрешения или незадолго до его начала). Показателями нормы считают концентрации не более 10 в 4 степени КОЕ/мл. Инфекции, вызываемые стрептококками этого типа при росте их концентраций, особенно опасны для новорожденных и людей пожилого возраста, для которых они чреваты уросепсисом, перитонитом и пневмонией, инфекциями костей и кожи.
Пути и условия инфицирования
К основным путям попадания бактерии рода агалактия в организм относят половой, бытовой, воздушно-капельный, пищевой, и пренатальный или интранатальный (от матери к новорожденному). Активное размножение стрептококков происходит на фоне нарушения баланса нормальной микрофлоры из-за ряда следующих факторов:
- ослабление иммунитета;
- нарушение правил интимной личной гигиены;
- регулярные спринцевания (у женщин);
- гормональные сбои;
- ношение нижнего белья из синтетических тканей;
- незащищенный сексуальный контакт.
Стрептококк агалактия у мужчин активизируется либо после секса без использования презерватива, либо на фоне дисбактериоза кишечника после антибиотикотерапии или в следствие влияния иных факторов. После первоначального инфицирования носитель становится способен передавать бактерию возбудителя своим половым партнерам (самый распространенный путь передачи инфекции).
Отдельную группу риска представляют собой новорожденные. По статистике, носителями стрептококка Agalactiae является около 30% всех здоровых женщин, у которых во время беременности на фоне гормональных изменений могут обостряться вызываемые патогенным микроорганизмом инфекции (циститы, уретриты и др.). Угроза заражения ребенка растет при следующих обстоятельствах:
- возраст матери старше 20 лет;
- аборты или выкидыши в медицинском анамнезе матери;
- преждевременные роды (до 37 недели);
- амнионит;
- хроническая инфекция мочеполовых путей;
- задержка внутриутробного развития;
- лихорадочный синдром во время родов.
Механизм воздействия на организм
Микроорганизмы типа агалактия при интенсивном размножении вызывают инфекционные заболевания мочеполовой системы, сопровождающиеся воспалительным процессом. Активность бактерии сопровождается выделением следующих соединений и токсичных веществ:
- Некротоксинов и летальных токсинов, провоцирующих некроз тканей.
- Лейкоцидина, разрушающего клеточный иммунитет.
- Стрептолизина, способствующего разрушению тканей.
- Амилаза, гиалуронидаза, протеиназа, способствующие распространению стрептококковой инфекции.
Характеристика возбудителя
Streptococcus – род факультативно-анаэробных грамположительных шаровидных микроорганизмов, устойчивых в окружающей среде. Стрептококки устойчивы к высушиванию, сохраняются в высушенных биологических материалах (мокрота, гной) несколько месяцев. При температуре 60 °С. погибают через 30 минут, под действием химических дезинфицирующих средств — через 15 минут.
Резервуар и источник стрептококковой инфекции – носитель стрептококковых бактерий или больной одной из форм инфекции человек. Механизм передачи – аэрозольный. Возбудитель выделяется больным при кашле, чихании, во время разговора. Заражение происходит воздушно–капельным путем, поэтому основными источниками заражения являются люди с преимущественным поражением верхних дыхательных путей (ангина, скарлатина). При этом на расстоянии более трех метров заразиться уже нельзя. В некоторых случаях возможна реализация алиментарного и контактного путей передачи (через грязные руки, зараженную пищу). Для стрептококков группы А при попадании в благоприятную питательную среду некоторых пищевых продуктов (молоко, яйца, моллюски, ветчина и др.) характерно размножение и длительное сохранение вирулентных свойств.
Вероятность возникновения гнойных осложнений при инфицировании стрептококками высока у лиц с ожогами, ранениями, беременных, новорожденных, больных после операций. Стрептококки группы В обычно вызывают инфекции мочеполовой сферы и могут передаваться при половых контактах. Новорожденные зачастую получают инфекцию в результате инфицирования околоплодных вод и при прохождении родовых путей. Естественная восприимчивость человека к стрептококковым бактериям высокая, иммунитет типоспецифический и не препятствует заражению стрептококками другого вида.
Стафилококки — это род бактерий, который развивается в нормальной кожной микрофлоре человека. Данный вид инфекции довольно распространен. Связано это с тем, что микробы бактерий очень распространены в окружающей среде. Особенности микробов в том, что они проникают в организм только через поврежденные кожные покровы или слизистые оболочки.
Пути передачи:
- контактно-бытовой;
- половой путь;
- самозаражение.
Фото стрептококковой и стафилококковой инфекции
Симптомы увеличения концентрации стрептококка агалактии
Бактерия стрептококк агалактия в моче или влагалищном мазке в увеличенных концентрациях свидетельствует о текущем воспалительном инфекционном процессе. В зависимости от типа инфекции, проявляется характерная симптоматика:
- При инфицировании мочевыделительных путей – зуд или жжение в области половых органов, цервикального канала, учащенные болезненные мочеиспускания, отечность и покраснение половых губ или анальных складок, боли в нижней части живота, выделения из мочеиспускательного канала.
- При стрептококковом тонзиллите (ангине), фарингите и др. бактериальных инфекциях дыхательных путей – лихорадка, признаки тяжелой общей интоксикации, поражение слизистых.
О чем говорят стрептококки в мазке из влагалища у женщин
Стрептококки в мазке у женщин – довольно частое явление. Эта бактерия одна из самых распространенных на Земле, она может обитать почти в любой среде, даже в неподходящих условиях и при ослаблении защитных сил организма существенно вредить здоровью человека. В обычном состоянии здоровья незначительное количество стрептококка отображает лишь естественный состав влагалищной среды.
Микроорганизмы могут распространяться по всему организму, но более благоприятные условия для их проживания имеются на коже и слизистых оболочках. Есть много вариантов обнаружения инфекции, но чтобы ее выявить достаточно провести исследование мазка.
Варианты заражения
Патологические симптомы возникают только в случае благоприятной среды для этого. Инфекция передается несколькими способами:
- контактно;
- половым путем;
- внутриутробное;
- воздушно-капельное заражение.
Повод для беспокойства – инфицирование дыхательных путей, такое случается при скарлатине или ангине.
Стрептококки сохраняют способность к жизнедеятельности порядка трех месяцев в порошковых биологических веществах. Симптомы заражения могут возникнуть во время контакта с инфекционным носителем или человеком с уже проявленными признаками болезни. При повышении температуры до 60 и более градусов вирус гибнет. Уничтожается бактерия также под влиянием химических веществ: моющих средств, шампуня и прочего. Причины размножения стрептококка следующие:
- сбои гормонального баланса;
- ослабление иммунных сил;
- заражение другими вирусами;
- хронические болезни, подрывающие защиту организма от инфекций;
- повышенная чувствительность к бактериям.
Вызывает распространение стрептококков также прием антибактериальных средств. Такое лечение негативно отражается на состоянии микрофлоры и провоцирует состояние, при котором отмечается преобладание кокков над другими бактериями.
Симптоматика
Стрептококковая инфекция в гинекологии может проявляться различными признаками, все определяется тем, какие заболевания развились вследствие активности бактерии. Но есть и характерные симптомы:
- болезненные ощущения и зуд промежности;
- выделения желтоватого цвета с кровянистыми примесями;
- острые или тянущие боли в нижней части живота, пояснице;
- сбои месячного цикла.
Вагинальная инфекция быстро лечиться при своевременном вмешательстве специалиста, не оставляя значительных последствий. Но если откладывать гинекологический осмотр, то бактерия вызывает серьезные осложнения.
Стоит отметить, что симптомы инфицирования стрептококком сильно напоминают проявление гонореи и потому их часто путают. Чтобы предельно достоверно определить причину патологического состояния и установить, что норма, а что отклонение, врач принимает решение о целесообразности проведения дифференциального обследования.
Стрептококки у беременных
Условно-патогенная бактерия может находиться в пищеварительной системе, симптомы не развиваются. Почти у 40% представительниц женского пола, вынашивающих ребенка, имеется стрептококк агалактия. Этот подтип инфекции можно обнаружить исключительно у беременных на 32-33 неделе срока. Бактерия сильно влияет на женский организм, может спровоцировать ранние роды или даже смерть плода.
Стоит обратить внимание: стрептококковая инфекция вызывает те же заболевания, что и золотистый стафилококк. Отличие заключается только в клинической картине болезни и в скорости развития патологии.
Есть факторы, повышающие вероятность распространения инфекции:
- выявление стрептококков подтипа В в моче;
- молодой возраст беременной, менее 20;
- угроза преждевременного начала процесса рождения;
- заражение инфекцией предыдущих детей.
Стрептококк подтипа агалактия преимущественно вызывает воспалительные и инфекционные процессы в мочеполовой системе, но случается и развитие таких заболеваний, как эндометрит, эндокардит, пневмония. Вынашивание ребенка сильно подрывает женский организм, в этот период иммунитет сильно ослаблен, поэтому вероятность распространения инфекции существенно повышается. Чтобы предупредить проблему, гинекология рекомендует внимательно относиться к состоянию своего здоровья и выполнять все правила относительно личной гигиены.
Лечебные мероприятия
Антибактериальная терапия инфекционной болезни – это норма, так как стрептококки устойчивы и сложно поддаются лечению. Препарат побирается после проведенного анализа, которым определяется реакция бактерии на те или иные средства. Лечение могут назначать разные специалисты: педиатр, терапевт, гинеколог, хирург и другие врачи. Все зависит от формы проявления инфекции.
При обнаружении первичных форм стрептококка чаще всего назначается прием антибактериальных средств пенициллинового ряда. Если пятидневный курс не привел к выздоровлению, то это признак подбора неправильного препарата, тогда антибиотик отменяют. Используют Эритромицин, Сумамед, Азитромицин, Цифран и так далее. Препараты тетрациклинового ряда не являются эффективными при лечении стрептококка.
Дополнительно применяются методы лечения, направленные на устранение симптомов, которые зависят от клинического проявления болезни.
При вторичном распространении инфекции проведение длительных курсов приема антибактериальных препаратов – это норма. Здесь применяют средства с пролонгированным действием. По необходимости дополняют терапию иммуномодулирующими средствами.
Особенности стрептококковой инфекции в гинекологии
Инфицирование стрептококком может произойти где угодно, бактерия присутствует везде и чаще всего поражает слизистые, ткани. Заражение может случиться в медицинском заведении, роддоме, общественном месте. Стрептококки проникают в организм при повреждении покровов.
Если имеется воспалительный процесс в органах, например, малого таза, то инфицирование может произойти при незащищенном половом акте. Патологические проблемы ослабляют женский организм, что повышает вероятность распространения инфекции.
Заключение
Именно стрептококки – наиболее распространенный вид, сохраняющий жизнеспособность практически в любой среде. Распространение патогенного микроба происходит при снижении способности организма сопротивляться заболеваниям. Бактерии проходят в дыхательную систему, где начинают стремительное размножение, отравляя вредоносными веществами.
Стрептококки могут существовать в любых органах, но наиболее благоприятные условия для них имеются на поверхности кожи, слизистых оболочках. Инфекция передается стандартными путями: контактно, воздушно-капельным способом и в процессе полового акта. Чтобы диагностировать заболевание, нужно сдать мазок на анализ.
Практически все люди во взрослом возрасте являются носителями стрептококка. В допустимых пределах бактерии являются составляющей обычной микрофлоры влагалища. Поэтому если мазок показал незначительное содержание кокков – 3-5%, то это не представляет опасности для здоровья и не требует специального лечения.
nashainfekciya.ru
Чем опасен стрептококк агалактия при беременности
Согласно статистике, стрептококки в мазке у женщин почти в 40% случаев обнаруживаются во время беременности. На фоне сниженного иммунитета максимально активное размножение агалактии наблюдается на 33-37 неделе, поэтому на этих сроках обязательно назначаются анализы для выявления возбудителя и его обезвреживания (при необходимости). Факторами, увеличивающими риск инфицирования, являются:
- обнаружения стрептококков этой группы в моче;
- диагностированная угроза преждевременных родов;
- диагностирование стрептококковой инфекции у предыдущих детей.
У беременной женщины агалактии могут вызывать воспаления мочеполовой системы, легких, спровоцировать следующие опасные осложнения беременности и родовой деятельности:
- эндометрит (воспаление внутренней оболочки матки);
- преждевременное отхождение околоплодных вод;
- хориоамнионит (воспаление плодных оболочек);
- выкидыш на любом сроке;
- преждевременное родоразрешение;
- сепсис, менингит, эндокардит(воспаление внутренней оболочки сердца) у новорожденного.
Стрептококковые вагиниты, лечение – Я – Женщина
- Стафилококковая и стрептококковая инфекция в гинекологии: лечение, симптомы и причины
- Стрептококк в мазке у женщин: лечение, причины
- Вагинит (кольпит), вульвовагинит, вульвит Причины вагинита (кольпита), вульвовагинита, вульвита
- Симптомы вагинита (кольпита), вульвовагинита, вульвита
- Диагностика вагинита (кольпита), вульвовагинита, вульвита
- Лечение вагинита (кольпита), вульвовагинита, вульвита
- Народные средства лечения вагинита (кольпита), вульвовагинита, вульвита
- Рекомендации во время лечения вагинита (кольпита), вульвовагинита, вульвита
- Осложнения вагинита (кольпита), вульвовагинита, вульвита
- Профилактика вагинита (кольпита), вульвовагинита, вульвита
- Вопросы и ответы акушера-гинеколога по теме вагинит (кольпит), вульвовагинит, вульвит
Микрофлора влагалища здоровой женщины содержит около ста различных микроорганизмов.
На долю условно-патогенных бактерий, грибков приходится не более 5%. Практически у каждой второй пациентки в мазке обнаруживают стрептококк или золотистый стафилококк.
Крепкая иммунная система сдерживает рост колоний этих микроорганизмов, поэтому назначать лечение целесообразно только в том случае, когда у женщин обнаруживается воспалительный процесс, который спровоцирован стрептококком или стафилококком.
Причины возникновения инфекций
На слизистой оболочке влагалища сосуществует огромное разнообразие грибков и микроорганизмов.
Здесь же живут и представители кокковой флоры:
- сапрофитный стафилококк;
- стрептококки группы В;
- эпидермальный стафилококк;
- золотистый стафилококк;
- зеленый стрептококк.
Пока иммунитет поддерживает равновесие микрофлоры, активного роста патогенных бактерий не происходит. Чтобы кокки начали размножаться, необходимы серьезные причины:
- Гормональный дисбаланс. Сбой гормонального фона приводит к уменьшению численности лактобактерий, в результате чего нарушается кислотно-щелочной баланс. Кислая среда создает благоприятные условия для размножения кокков.
- Механическое повреждение слизистой оболочки влагалища. Стрептококковая и стафилококковая инфекция очень часто возникает после родов, абортов, инструментальной диагностики.
- Злоупотребление антибиотиками. Когда снижается местный иммунитет.
- Хронические патологии пищеварительных органов. Язва желудка и 12-перстной кишки, гастрит, нарушение в работе кишечника.
- Пренебрежительное отношение к личной гигиене. При неправильном подмывании стрептококки попадают из кишечника во влагалище. Особо благоприятной средой для размножения кокков считаются менструальные выделения. Поэтому гинекологи настаивают на тщательной гигиене наружных половых органов во время месячных.
- Последствия инфекционных заболеваний. Кокковая инфекция часто появляется на фоне сниженного иммунитета во время эпидемий гриппа, ОРВИ.
Если женщина не является носительницей стрептококка или стафилококка, она может заразиться им во время незащищенного полового контакта. Кокки проникают через микроповреждения слизистой оболочки и существует в латентном состоянии.
Косвенные причины развития кокковой инфекции:
- нерегулярный менструальный цикл;
- частые спринцевания;
- эндокринные заболевания (диабет);
- гормональные заболевания у женщин (миома, эндометрит)
- контактный дерматит (сильная аллергическая реакцияна синтетическое белье)
- лечение в отделении гинекологии (инфекцию заносят во время различных манипуляций).
Урогенитальные заболевания, вызванные кокками, имеют яркую симптоматику и лечатся антибактериальными препаратами.
Клинические проявления и диагностика инфекций
В гинекологии стрептококковая или стафилококковая инфекции вызывают такие заболевания:
- уретрит;
- цистит;
- вагинит (вульвовагинит);
- цервицит;
- цервиковагинит;
- аднексит;
- сальпингит.
Острая стадия вышеперечисленных заболеваний у женщин имеет ярко выраженные симптомы:
- изменение количества, цвета и запаха выделений из влагалища (золотистый стафилококк приводит к появлению выделений с желтоватым оттенком);
- боль в области поясницы или в нижней части живота (появляется при аднексите или сальпингите);
- зуд и жжение половых органов, вызванные обильным выделением слизи;
- повышение температуры тела (до 38°С);
- болезненные ощущения во время интимных отношений;
- нарушение мочеиспускания: болезненность, частые позывы, мутная моча, небольшие порции мочи во время каждого посещения туалета, тянущая или ноющая боль над лобком;
- выделения с примесью гноя;
- оранжевые чешуйки на половых губах (признак золотистого стафилококка)
При внешнем обследовании обнаруживаются другие симптомы: слизистая оболочка влагалища приобретает малиновый оттенок, становится отечной, вероятно наличие мелкоточечных кровоизлияний. Иногда в отделяемом из влагалища у женщин наблюдают частички крови.
Подобные симптомы характерны для острого течения болезни. Хроническая стрептококковая инфекция в гинекологии имеет более стертые признаки. Дальнейшее лечение будет зависеть от результатов исследования. Основной метод исследования у женщин: мазок содержимого влагалища. Золотистый стафилококк имеет схожие симптомы с гонококком, поэтому так важно правильно установить возбудителя инфекции.
В качестве вспомогательный анализов могут использоваться:
- ПЦР-диагностика;
- бактериологический посев на среду;
- общий анализ мочи;
- клинический анализ крови.
Чтобы получить достоверный ответ, за неделю до предполагаемого исследования рекомендуется прекратить использование вагинальных свечей, спреев или таблеток. За два дня до анализа следует исключить половые отношения и спринцевания. Последнее подмывание проводится вечером накануне анализа, утром подмываться не нужно.
Результаты исследования у женщин обычно приходят спустя несколько дней. Существует возможность пройти экспресс-тест на возбудителя. В этом случае золотистый стафилококк или стрептококковая инфекция определяется в течении получаса. Лечение подбирается индивидуально каждой пациентке ввиду особенностей диагноза, возраста и сопутствующих заболеваний.
Антибиотикотерапия против инфекции
Наиболее эффективно лечение инфекции у женщин препаратами пенициллинового ряда. Снять симптомы и остановить размножение кокковой флоры помогает комплексная терапия: системное лечение антибиотиками и свечи для местного использования.
Антибактериальное лечение кокковой инфекции пенициллинами (в том числе и золотистого стафилококка):
- Амоксициллин;
- Амоксиклав;
- Флемоклав;
- Аугментин;
- Азитромицин;
- Азитрал;
Препараты цефалоспоринового ряда:
- Цефалексин
- Цефуроксим;
- Цефазолин;
- Цефтриаксон;
- Супракс.
Лечение обычно занимает от 7 до 10 дней. Запрещается корректировать дозировку или отменять препарат самостоятельно. Для скорейшего выздоровления лечение у женщин подкрепляется применением средств местного назначения.
Антибактериальные свечи:
- Ливарол. Активный компонент: кетоконазол. Назначается при грибковых, стафилококковых и стрептококковых инфекциях по 1 суппозиторию на 10 дней.
- Полижинакс. Свечи, которые используются в терапии бактериального вульвовагинита, неспецифического кольпита. Лечение длится 12 дней, применяется по одной свече на ночь ежедневно.
- Бетадин. Йодсодержащие свечи, применяемые при лечении стрептококкового или стафилококкового вагинита. Возможны побочные эффекты: зуд слизистой оболочки влагалища, жжение, покраснение и отек после использования. Продолжительность терапии составляет 7 либо 14 дней (в зависимости от стадии болезни).
- Залаин. Вагинальные свечи, применяемые в комплексной терапии грамположительных видов стрептококков и стафилококков (бактериальный вагиноз). Суппозиторий вводится однократно.
- Гексикон. Свечи, содержащие антисептик хлоргексидин. Разрешены для лечения бактериальных вагинитов во время беременности. Стандартный курс лечения длится 7 дней.
- Тержинан. Комбинированный препарат, часто применяемый в гинекологической практике. Сульфат неомицина, который содержат свечи, губителен для стафилококка (на стрептококки неомицин не действует). Терапия длится минимум 7 дней.
- Клион Д. Свечи, угнетающие рост колоний стрептококка. Препарат показан при бактериальных вагинозах. Особенности лечения: по 1 шт. на протяжении 7-10 дней.
Лечение у женщин обычно закрепляют назначением препаратов для восстановления микрофлоры влагалища. Хорошо зарекомендовали себя свечи Гинофлор, Вагисан, Вагилак.
Чтобы избежать заражения кокковой инфекции, необходимо использовать презервативы с новым партнером, своевременно лечить заболевания репродуктивной сферы, носить качественное удобное белье и следить за гигиеной половых органов.
Соблюдение элементарных правил гигиены поддержит состояние местного иммунитета. В случае обнаружения неприятных признаков кокковой инфекции, следует немедленно обратиться к врачу. Раннее начало терапии обеспечивает благоприятный прогноз на выздоровление.
Дайте нам об этом знать – поставьте оценку (2 votes, average: 3,50
Диагностика
Обнаруживается стрептококк агалактия в мазке из влагалища, уретры или прямой кишки, который может быть назначен при обнаружении кокковой флоры в анализе мочи. После обследования биоматериала методом лабораторной микроскопии проводят посев на питательную среду, помогающий точно идентифицировать тип бактериального заражения, степень концентрации микроорганизмов и их устойчивость к антибактериальным препаратам.
Дополнительно назначаемыми анализами являются скрининг-тесты: ИФА (иммуноферментный анализ) и метод ПЦР (полимеразно-цепной реакции). Остальные лабораторные и инструментальные методы диагностики (общий и биохимический анализ крови, мочи, УЗИ и пр.) назначаются для выявления заболеваний, развитие которых вызвано активным размножением Streptococcus agalactiae.
Как происходит забор биоматериала
Существует несколько способов выявления повышенного уровня содержания стрептококка агалактия в организме человека.
Предлагаем ознакомиться Паутинный клещ на розе: как бороться и чем обработать растение
Чаще всего для исследования производят забор следующих биологических материалов:
- мазок со слизистой оболочки влагалища;
- мазок со слизистой оболочки дыхательных путей;
- мазок со слизистой оболочки уретры;
- мокрота из полости носа;
- кровь;
- моча;
- соскоб с кожного покрова.
| Название исследование | Описание методики |
| Общий анализ крови | Производится забор капиллярной крови из безымянного пальца. |
| Биохимический анализ крови | Производится забор венозной крови из вены. |
| Биохимический анализ мочи | Производится самостоятельный забор мочи естественным путем в баночку (перед этим нужно обязательно помыться) или сдача мочи в больнице через катетер. |
| Общий анализ мочи | |
| Бактериологический посев биологического материала | Забор биологического материала путем взятия образца специальным шпателем, которые затем наносится на покровное стекло и равномерно распределяется. |
| Ультразвуковое исследование | Производится изучение состояния внутренних полостей с помощью аппарата УЗИ. |
Лечение streptococcus agalactiae
Необходимость медикаментозного лечения возникает при обнаружении концентраций стрептококков этой группы до 10 в четвертой степени КОЕ/мл и выше, даже если инфекция протекает скрыто. При воспалении мочеполовых органов терапию проходят оба половых партнера, при инфекции смешанного типа возможен прием антибиотиков разных фармакологических групп, при хронической форме заболевания пациенту с острой стадией болезни рекомендован прием иммуностимуляторов, ферментов, прохождение курса физиотерапии.
В зависимости от типа инфекции антибактериальные препараты назначаются в форме средств для перорально приема или в иных лекарственных формах (например, вагинальные таблетки или свечи Флуомизин, Тержинан, Гексикон,). Активность по отношению к агалактии проявляют пенициллины (Оксациллин, аминопенициллины), макролиды (Эритромицин) и Цефалоспорины (Цефазолин).
Если существует опасность заражения ребенка во время родов, матери назначаются внутривенные инъекции, проводимые прямо при родоразрешении, может рекомендоваться антибактериальная санация родовых путей перед родами. После курса антибиотиков и выведения бактерии требуется терапия с применение пробиотиков или энтеросорбентов (например, Атоксила) для восстановления естественной нормальной микрофлоры кишечника.
Терапия стрептодермии
Медикаменты назначают соответственно возрастной категории пациента и его индивидуальному физиологическому состоянию. Чем раньше человек обратился к врачам, тем быстрее осуществляется регенерация клеток и скорее наступает эффект от лекарственного воздействия.
Лечение стрептодермии консервативными методами сводится к следующему:
- обработка ран дезинфицирующими веществами;
- накладывание на повреждения мази, геля;
- инъекции;
- физиопроцедуры УФОК, УФО (облучение ультрафиолетом крови, поражённой кожи);
- витаминотерапия;
- приём антигистаминных и иммуномодулирующих препаратов;
- диета.
Чтобы ускорить лечение, пациенту требуется соблюдать медицинские рекомендации и строгие санитарные условия: тщательная гигиена, стерильность инструментов и рук при обрабатывании ранок, дезинфекция личных вещей.
Антисептические средства при стрептодермии
Чтобы прекратить распространение бактерий и подсушить ранки, для обработки кожи в случае стрептококковой инфекции применяют спиртовые и водные дезинфицирующие растворы. Тип средства подбирают в зависимости от локализации повреждений на коже.
Хлоргексидином, перекисью, Метиленовым синим, Мирамистином, марганцовкой и другими водными растворами обрабатывают область вокруг глаз, губы, слизистые оболочки. Этими препаратами также при стрептодермии проводят лечение младенцев, людей с чувствительной кожей, либо если подтверждён аллергический дерматит, к которому подсоединилась инфекция.
Спиртовыми растворами: зелёнкой, синькой, йодом, Фукорцином, Борной или Салициловой кислотой — нельзя обрабатывать мокнущие ранки, слизистые оболочки, губы, веки, кожный покров при индивидуальной непереносимости препарата. Запрещены они при возрастных или других противопоказаниях к применению.
Перед обработкой кожи при стрептодермии следует продезинфицировать руки. Все действия проводят стерильными ватными либо марлевыми тампонами. Если в области повреждения образовались пузырьки с гноем (буллы, фликтены), их прокалывают, затем повторно применяют антисептик. В процессе обработки сыпи также захватывают здоровую кожу примерно на 1 см вокруг высыпаний. Процедуру повторяют до 4 раз в день, а через полчаса по завершении манипуляции применяют средства для местной терапии.
Другие медикаменты в лечении стрептодермии
После обработки эрозий надо использовать мази, гели или пасты, в состав которых вошли противомикробные и антисептические вещества. Местную терапию продолжают, пока полностью не заживут ранки. При стрептодермии препараты наносят на очищенную водными либо спиртовыми растворами сухую поверхность повреждений. Если же доктор назначил применение препаратов в виде компресса, процедуру проводят дважды в день: густо смазывают средством ранку, сверху покрывают марлевой салфеткой, закрепляют бинтом либо лейкопластырем и оставляют на 30-60 минут, согласно указаниям в инструкции.
При стрептодермии помогут снять воспаление, остановить развитие стрептококка и других микробов такие медикаменты, как Резорцин, Циндол,
Полезно также обрабатывать поврежденную кожу мазями, содержащими антибиотик: Эритромициновая, Тетрациклиновая, Гентамициновая, Левомеколь, Стрептоцид, Синтомицин.
При стрептодермии врач назначает приём витаминов группы B (рибофлавин, тиамин, фолиевую кислоту, пиридоксин, кобаламин), а также A, C, D, E, K, PP, H. Они улучшают регенерацию клеток, очищают организм от продуктов жизнедеятельности микроба, нормализуют обмен веществ.
Иногда лечение проводят с применением глюкокортикостероидов — препаратов, содержащих гормоны. Врач назначает Пимафукорт, Целестодерм B, Лоринден C и другие мази, если у пациента со стрептодермией сочетается экзема, атопический дерматит, язвы, аллергия на антисептики.
При эктиме, множественных повреждениях кожи инфекцией, ослабленном иммунитете, осложнениях врач назначает Оспамокс, Амоксициллин, Бактоклав, Фромилид, Азицин и прочие антибиотики. Применяя этот тип лекарств, пациент должен параллельно пить пробиотики, чтобы нормализовать кишечную микрофлору.
Чтобы предотвратить распространение стрептодермии на новые участки тела, не рекомендуется купаться, расчёсывать ранки. Разрешено протирать кожу ромашковым настоем, а на высыпания накладывать влажные примочки, смоченные в травяных или дубовой коры отварах, чтобы уменьшить зуд и воспаления. В целях профилактики нужно своевременно обрабатывать антисептиком укусы насекомых, царапины и ранки, а также соблюдать личную гигиену.
Этиология
Streptococcus agalactiae — бактерия специфической шарообразной или эллипсоидной формы, способная существовать как в присутствии кислорода, так и без него. Микробы аспорогенны, неподвижны, имеют капсулу и обладают группоспецифическим полисахаридом.
Streptococcus agalactiae под микроскопом
Микроорганизмы окрашиваются по Грамму в синий цвет и располагаются в мазке парами и цепочками. Они требовательны к питательным средам. Растут стрептококки исключительно на средах, содержащих кровь, сыворотку и глюкозу. Эти вещества они используют в качестве источника энергии. Инкубируют посевы в термостате при 37 °С, хотя бактерии способны расти и в более широком диапазоне температур. На кровяном агаре спустя сутки образуются сероватые, очень мелкие колонии с зоной полного просветления по периферии. В бульоне бактерии растут в виде диффузной мути и осадка на дне пробирки.
Патогенные свойства бактерии обусловлены следующими факторами:
- Стрептолизином, разрушающим окружающие ткани, в особенности клетки крови и сердца;
- Лейкоцидином, угнетающим иммунитет и уничтожающим иммунокомпетентные клетки;
- Некротоксином, вызывающим отмирание тканей и воздействующим на работу всего организма;
- Ферментами, обеспечивающими адгезию, инвазию, распространение микробов по организму, поражение здоровых тканей и развитие патологического процесса.
Стрептококки резистентны к замораживанию, высушиванию, прямым солнечным лучам. Погибают бактерии под воздействием антибиотиков, антисептиков и дезинфектантов.
Патогенетические звенья инфекции:
- Внедрение микроба в организм,
- Колонизация слизистой оболочки,
- Возникновение очага воспаления,
- Боль и отек,
- Бактериемия,
- Общее недомогание,
- Интоксикационный синдром,
- Дегидратация,
- Помутнение сознания,
- Регионарный лимфаденит.
Эпидемиология
В природе Streptococcus agalactiae широко распространены. В организме человека они колонизирует слизистую кишечника, носа, глотки, органов выделительной и половой систем. От 15 до 40 % женщин репродуктивного возраста являются бактерионосителями.
Существует три варианта пребывания стрептококка во влагалище:
- Безвредное существование бактерий в организме,
- Бактериальный вагиноз,
- патологический процесс.
Если бактерий в мазке из цервикального канала мало, а лактобактерий много, говорят о первом варианте. Когда количество стрептококков превышает количество молочнокислых бактерий, а число лейкоцитов в поле зрения находится в пределах 50, это признак дисбиоза влагалища. Если лейкоцитов гораздо больше, значит, имеет место воспалительный процесс, протекающий в форме цервицита, кольпита, эндометрита.
Пути распространения инфекции:
- Контактный — через общие бытовые предметы, при поцелуе, объятии,
- Самозаражение – микробы из анальной зоны могут проникать во влагалище,
- Вертикальный — заражение плода во время беременности или новорожденного в родах,
- Половой — во время коитуса без презерватива,
- Воздушно-капельный — при чихании, кашле, близком общении с больным человеком,
- Пищевой — при употреблении обсемененных продуктов питания,
- Гематогенный занос инфекции из первичных очагов – почек или носоглотки.
Новорожденные инфицируются в первые часы и сутки после рождения. Это может случиться и раньше: в пре- и интранатальном периоде.
Для Streptococcus agalactiae характерна осенне-зимняя сезонность. Эти микроорганизмы активизируются в тот момент, когда организм ослаблен вирусами. На фоне ОРВИ чаще всего развивается вторичная бактериальная инфекция.
Факторы, способствующие активации стрептококка и его размножению:
- Гормональный сбой,
- Иммунодефицит,
- Тяжелые соматические заболевания,
- Частое использование лубрикантов,
- Ношение нижнего белья из синтетических материалов,
- Эндокринопатии,
- Вирусные инфекции,
- Дисбиоз кишечника,
- Неправильное подмывании наружных половых органов,
- Редкая смена нижнего белья,
- Использование некачественных гигиенических средств,
- Половой акт без презерватива,
- Стрессы,
- Переохлаждения,
- Состояния после хирургических вмешательств,
- Длительная и бесконтрольная антибиотикотерапия,
- Лечение цитостатиками или гормонами,
- Физическое перенапряжение,
- Сложная экологическая обстановка.
В мужской организм бактерии попадают при незащищенном половом контакте с женщиной-бактерионосителем или в результате дисбиоза кишечника. Инфицирование происходит во время занятий нетрадиционными видами секса. Мужчина-носитель инфекции сам не болеет, но заражает своих партнерш.
При беременности изменяется гормональный фон, что выражается в повышенной секреции прогестерона, угнетающего локальную иммунную защиту. Подобные процессы позволяют сохранить беременность. При этом повышается риск развития инфекционных патологий и обострения хронических заболеваний органов репродуктивной системы.
Группы риска
Как показывает практика процент инфицирования вырастает при:
- переохлаждении организма;
- если у женщины нерегулярный менструальный цикл;
- если женщина использует часто спринцевание половых органов;
- нарушение обмена веществ;
- нарушение питания;
- хронические заболевания, которые снижают иммунитет, например, бронхит;
- эндокринные заболевания;
- гормональные заболевания;
- дерматит;
- длительный приём антибиотиков.
Клиника
Инфекция, вызванная данным микроорганизмом, у лиц репродуктивного возраста обычно протекает бессимптомно. Клинические признаки воспаления органов мочевыделительной и репродуктивной систем вполне узнаваемы.
Streptococcus agalactiae способен вызвать воспаление мочевого пузыря, уретры, легких, эндокарда, суставов, мозговых оболочек.
- Цистит проявляется режущей болью при мочеиспускании, отсутствием удовлетворения от его опорожнения, императивными позывами, появлением мутной мочи с хлопьями. Острая форма патологии сопровождается интоксикацией, слабостью, цефалгией, резкой потерей работоспособности.
- Симптомами уретрита у мужчин являются: боль при мочеиспускании, неприятные ощущения, чувство жжения в уретре, усиливающиеся после эякуляции, обильное слизисто-гнойное отделяемое, гиперемия устья и отек губок уретры по утрам.
- Бактериальный вагиноз, обусловленный увеличением во влагалище стрептококка, проявляется жжением и зудом в промежности, ноющей болью внизу живота, болезненностью при половом сношении, отеком половых губ, обилием желтоватой слизи.
Диагностика
Заболевание диагностируют на основании результатов анализов. Лабораторная диагностика — основной способ обнаружения Streptococcus agalactiae.
- В микробиологической лаборатории исследуют мазки из цервикального канала, влагалища, зева, мочу, кал. Окрашенные препараты микроскопируют и обнаруживают кокковую флору. В лаборатории готовят жидкие и плотные питательные среды, содержащие стимуляторы роста для стрептококков и вещества, подавляющие постороннюю микрофлору. На основании полученных в ходе исследования данных о
морфологических, тинкториальных, культуральных и биохимических свойствах выделенный микроб относят к виду Streptococcus agalactiae. Для клиницистов важен не сколько сам микроб, сколько его устойчивость к антибактериальным препаратам и бактериофагам. Для этого ставят специальный тест — антибиотикограмму с представителями основных групп противомикробных средств широкого спектра действия. Значения, превышающие 10 4 степени КОЕ/мл, указывают на этологическую роль данного микроорганизма в развитии заболевания.
- Экспресс-диагностика — серологическое исследование: реакция агглютинация, иммуноферментный анализ, коагглютинация. Эти методы быстро дают результат, который не всегда оказывается достоверным. При заборе биоматериала от роженицы отделяемое влагалища может смешаться с кровью или амниотической жидкостью, что отрицательным образом повлияет на точность результата.
- ПЦР-диагностика позволяет быстро и точно обнаружить генетический материал стрептококка в образце: моче, влагалищном секрете, кале. Не смотря на универсальность данного метода, современные стандарты требуют подтверждения полученных результатов «классическим» бактериологическим способом.
- Клинические анализы крови и мочи – стандартные диагностические методики, выявляющие признаки воспаления и дисфункции внутренних органов.
Экспресс-тест
Streptococcus Agalactiae у женщин легко выявить с помощью взятия на анализ мазка. Это исследование обладает высокой достоверностью, однако для получения результатов потребуется около 24 часов.
В крайних случаях, если состояние пациентки тяжелое, необходимо получить информацию срочно. В таких случаях прибегают к помощи экспресс-теста. Приобрести его также можно в любой аптеке и сделать срочную диагностику самостоятельно.
Предлагаем ознакомиться Лекарственные средства для повышения иммунитета
Для этого нужно:
- Снять с упаковки обертку и вынуть пробирки.
- В одну из пробирок добавить по 4 капли каждого цвета (в упаковке есть 2 жидкости: красная и желтая).
- Тщательно перемешать жидкости путем встряхивания (10-15 раз) и оставить в покое на 60 с.
- Произвести забор биологического материала с помощью чистой ватной палочки из зева.
- Поместить палочку с биоматериалом в пробирку с раствором на 60 с.
- Вынуть палочку и отжать в другую пробирку (пустую).
- Опустить тестовую полоску в отжатую жидкость на 5 мин.
По истечении 5 мин. можно смотреть результат. На тест-полоске появится:
- 1 полоска – это значит, что результат отрицательный и в организме нормальное содержание стрептококков;
- 2 полоски – тест положительный, следовательно, концентрация бактерий превышена.
Значительным недостатком данного метода диагностики является низкая достоверность, потому что тест часто ошибается. Это происходит из-за того, что во внешней среде бактерии сохраняют жизнеспособность недолго, а при обработке раствором они живут не более 15 мин.
Лечебные мероприятия
Чтобы избавиться от патологии и ее основных проявлений, необходимо воздействовать на первопричину — убить бактерии. Для этого больным назначают противомикробные препараты — антибиотики. В тяжелых случаях показано патогенетическое лечение, включающее дезинтоксикацию и коррекцию водно-электролитного баланса. Симптоматическая терапия заключается в применении жаропонижающих, антигистаминных, антисептических средств. Дополнительно проводят лечение иммуномодуляторами и иммуностимуляторами.
- Этиотропное лечение необходимо при выявлении Streptococcus agalactiae в количестве 10 5 степени КОЕ/мл. Оно проводится антибиотиками из основных фармакологических групп: пенициллины- «Амоксиклав», «Аугментин», цефалоспорины – «Цефазолин», «Цефоперазон», макролиды – «Сумамед», «Клацид». Стандартный курс антибактериального лечения составляет 7-10 дней.
- При цистите или уретрите проводят инстилляции мочевого пузыря антибиотиками, к которым чувствителен выделенный микроб. Местная терапия имеет преимущество перед системными методами лечения. Это объясняется воздействием лекарственного средства только на очаг заболевания.
- В тяжелых случаях, когда нет эффекта от антибактериальной терапии или она противопоказана, проводят лечение стрептококковым бактериофагом, представляющим собой вирус, который уничтожает стрептококки.
- Всем женщинам, планирующим беременность, показано санирование влагалища, которое уменьшит риск заражения новорожденного. Для этого применяют вагинальные таблетки «Флуомизин», «Тержинан», «Гексикон». Это комплексные препараты, действующее вещество которых обладает противогрибковым, антибактериальным и противовоспалительным действием.
- Иммуномодулирующая терапия – «Иммунал», «Имунорикс», «Полиоксидоний».
- Пре- и пробиотики – «Бифидумбактерин», «Бифиформ», «Аципол».
- Энтеросорбенты – «Атоксил», «Энтерол», «Полисорб».
- Дезинтоксикация и дегидратация — внутривенное введение коллоидных и кристаллоидных растворов.
- Диуретики для выведения из организма токсинов с мочой и снятия интоксикации – «Верошпирон», «Диакарб», «Маннитол».
- Для уменьшения отечности слизистой и устранения зуда показано применение антигистаминных средств – «Супрастина», «Зодака», «Диазолина».
- Жаропонижающие препараты при лихорадке – «Нурофен», «Ибупрофен», «Парацетамол».
- Местные антисептики для промывания носа и полоскания горла – «Фурацилин», «Хлорофиллипт», «Аквалор».
- Поливитамины и минеральные комплексы.
После купирования интоксикации назначают физиопроцедуры – электрофорез, УВЧ, индуктотермию, СВЧ-терапию, аэроионотерапию, ингаляции, а также массаж грудной клетки, иглоукалывание, ЛФК.
Большое значение в лечении патологии имеет режим. Больным рекомендуют находиться в постели, особенно лицам с выраженным интоксикационным синдромом. Активные движения в разгар болезни замедляют процесс выздоровления и повышают риск развития серьезных осложнений. Дезинтоксикационные мероприятия включают правильный питьевой режим — употребление в сутки до трех литров воды. При отсутствии эффекта от лечения и ухудшении общего состояния больным показана госпитализация в стационар.
Своевременное и правильное лечение делает прогноз инфекции благоприятным. В противном случае заболевание приобретает затяжное течение, развиваются тяжелые осложнения, возможен смертельный исход.
Видео: доктор Елена Березовская – стрептококк группы В и беременность
Профилактика
Мероприятия, предупреждающие развитие стрептококковой инфекции:
Streptococcus agalactiae в определенном количестве постоянно обитает в организме здоровых людей. Его активация и быстрое размножение очень опасны. Микроб разрушает эритроциты и способствует развитию воспаления там, где его количество максимально. При своевременном обнаружении стрептококка и правильном этиотропном лечении прогноз на выздоровление улучшается, и значительно снижается риск развития опасных для жизни осложнений.
Стрептококк агалактия оседает преимущественно в мочеполовой системе и кишечнике, приводит к развитию инфекционных заболеваний у молодых матерей и младенцев. Рассматриваемая стрептококковая инфекция относится к микрофлоре условно-патогенного характера, возбудителем которой является бета-гемолитический стрептококк.
Стрептококк агалактия – единственный представитель стрептококков группы В
Когда нарушается баланс микрофлоры влагалища
Большая часть от нормальной флоры влагалища – палочки лактобактерий. К условно-патогенной флоре относят стрептококки, стафилококки, кандиды, гарднереллы, уреаплазмы и микоплазмы. Если количество этих микроорганизмов не превышает норму, состояние влагалища будет удовлетворительным.
Одним из возбудителей неспецифического воспаления выступает стрептококк агалактия. Группа стрептококков включает большое количество разных микроорганизмов схожих по морфологическим признакам. По типу роста на питательной среде различают гемолитические, негемолитические и зеленящие микроорганизмы.
В среде влагалища встречаются стрептококки групп В и D, а также зеленящие. Агалактия – бета-гемолитический стрептококк из группы В. Норма стрептококков составляет 10 в 4 степени КОЕ/мл.
Заселение стрептококков в среду влагалища происходит в пубертатный период, особенно в начале половой жизни. Возможно и самозаражение из анальных складок, если во время подмывания направлять движения от анального отверстия.
Группы риска:
- женщины, которые перенесли преждевременные роды;
- повышение температуры во время родов;
- безводный промежуток более 18 часов;
- рождение недоношенного ребенка;
- младенцы с недостаточным весом;
- кесарево сечение;
- наличие бактерий в моче.
Во время родов женщина может инфицировать новорожденного. Стрептококки передаются также бытовым путем через предметы гигиены общего пользования. Мужчина может инфицироваться во время орального или анального контакта.
Пока стрептококков в среде влагалища мало, преобладают лактобактерии. В большом количестве они могут подавлять рост условно-патогенной флоры и защищать от воспаления. Стрептококк активизируется при дисбалансе микрофлоры влагалища.
Причины нарушения баланса микрофлоры:
- гормональные изменения;
- ослабление иммунитета;
- несоблюдение правил личной гигиены;
- спринцевание;
- тяжелые системные патологии (сахарный диабет).
Во время беременности воспаление развивается сразу из-за двух факторов (иммунитет и гормоны). Повышение уровня прогестерона негативно сказывается на местном иммунитете, что необходимо для сохранения беременности. Однако на этом фоне нередко обостряются латентные инфекции мочеполовой системы.
Мужчина инфицируются во время незащищенного полового акта. Он становится носителем и передает стрептококк своим половым партнерам.
Стрептококк агалактия – что это такое
Streptococcus agalactiae – единственный вид стрептококков, который относится к группе В. Выявление этой бактерии в мазке, взятом из цервикального канала, свидетельствует о наличии неспецифического воспалительного процесса.
Во время проведения микроскопических исследований микроб окрашивается по Грамму. Если после промывания он не теряет цвета, то инфекцию относят к грамположительным бактериям.
Стрептококк под микроскопом
Когда нужно лечиться и какими препаратами при выявлении стрептококка группы В
Streptococcus Agalactiae в мазке у женщин нуждается в своевременном лечении. Однако перед тем как его начать, необходимо сходить на прием к врачу и сдать все необходимые анализы. После установки диагноза лечение нужно начать сразу.
К терапии против данной группы микроорганизмов нужно подходить комплексно и совмещать несколько методов лечения, к которым относятся:
- прием антибактериальных препаратов;
- укрепление общего состояния иммунной системы;
- меры по восстановлению нормальной концентрации микроорганизмов во флоре кишечника (она нарушается из-за приема препаратов против бактерий);
- обезвреживание и выведение токсических веществ из организма;
- прием антигистаминных препаратов (назначается в случае появления аллергических реакций, особенно у детей);
- симптоматическое лечение сопутствующих симптомов болезни;
- лечение заболеваний, которые протекают параллельно из-за ослабления иммунитета (при наличии).
Противодействие бактериям, в основном оказывают, используя следующие препараты:
- Азитромицин;
- Ампициллин;
- Эритромицин;
- Цефотаксим;
- Спирамицин;
- Кларитомицин.
Прием антибиотиков широкого спектра действия в таких случаях нежелателен, потому что они могут спровоцировать усиленный рост патогенной микрофлоры. Длительность лечения определяется индивидуально. Обычно оно продолжается от 5 до 10 дней, в зависимости от тяжести заболевания.
Причины появления стрептококка агалактия
ВАЖНО ЗНАТЬ! Средство для избавления от паразитов, которое действует сразу. Читать далее >>>
Микроб заселяет организм во время полового созревания и в начале интимных отношений. Места обитания бактерии – прямая кишка, носоглотка и урогенитальный тракт.
Чтобы паразиты вышли, необходимо всего лишь пить натощак.
Существуют несколько путей передачи инфекции:
- воздушно-капельный;
- бытовой;
- пищевой;
- половой;
- от матери к младенцу.
Причины и способы попадания инфекции
Источником заражения патогенных стрептококков является больной человек или здоровый носитель этих бактерий. Стрептококковая инфекция может передаваться несколькими путями:
- аэрозольный или воздушно-капельный
(при кашле, чихании, разговоре, поцелуях – с частичками слюны выделяются бактерии); - контактно-бытовой
(бактерии передаются при контактировании с предметами, посудой, бельём, которыми пользовался болеющий человек); - половой
(передача возбудителей происходит через половой акт); - вертикальный
(заражение возникает при беременности и родах от матери к ребенку).
Недостаточно обработанные медицинские инструменты, несоблюдение гигиены, а также употребление некачественных продуктов питания могут стать причиной заражения стрептококком.
Симптомы присутствия бактерии в организме
Ярко выраженные симптомы наличия стрептококка агалактия отсутствуют, поскольку инфекция не приводит к развитию воспалительных процессов во влагалище. Значительное превышение нормы концентрации бактерии в организме выявляют во время плановых осмотров.
Однако при значительном росте количества бактерии в организме женщины возникает ряд негативных симптомов:
- жжение и зуд в области влагалища;
- развитие воспалительных процессов;
- тянущая боль в области яичников при интимной близости;
- отёчность половых губ;
- наличие выделений, чаще всего имеющих жёлтый оттенок.
У мужчин обострение инфекции характеризуется болезненным мочеиспусканием и жжением уретры, наличием слизистых выделений.
Отёк половых губ – один из признаков деятельности вредных бактерий
Симптомы болезни
Как правило, точной симптоматики у такого заболевания нет. Все будет зависеть от того, насколько велико поражение участок на теле пациента. Во время своей жизнедеятельности этот возбудитель выделяет вредные для организма токсины, которые приводят к появлению неприятных ощущений у больного. Самыми типичными признаками являются:
- Увеличение или снижение уровня температуры.
- Высыпания на коже.
- Скачки артериального давления.
- Проблемы с мочеиспусканием.
- Высыпания на кожных покровах.
- Болезненные ощущения в области почек.
Сначала у заболевшего появляется покраснение на участках кожи, которое перерастает в гнойную инфекцию. Если слегка надавить на пораженное место, можно почувствовать боль. Такое состояние свидетельствует, что болезнь перешла в острую стадию.
Пациентам со стрептококком следует помнить, что при несвоевременном обращении к врачу, в их кровь могут проникнуть токсины, что может спровоцировать шоковое состояние. Поэтому специалисты рекомендуют при первых симптомах такой болезни немедленно обратиться в медицинское учреждение для проведения диагностики и назначения лечения.
Диагностика
Заболевание диагностируют на основании результатов анализов:
Любых паразитов можно выгнать дома. Просто не забывайте один раз в день выпивать.
- общий и биохимический анализ крови и мочи – необходим для определения антител;
- УЗИ внутренних органов;
- мазок на флору, который позволяет определить степень чистоты влагалища;
- наличие стрептококка выявляют в посеве, материал для которого берётся из аноректальной области или влагалища. Для наиболее точного результата рекомендуется брать анализ одновременно с нескольких участков слизистой;
- ПЦР-диагностика – позволяет выявить инфекцию в моче. Главный недостаток – невозможно определить устойчивость бактерии к антибиотикам, поскольку невозможно выявление живых представителей стрептококковой инфекции.
Выявить стрептококков помогает мазок на флору
Что может повлиять на достоверность исследования?
Исказить достоверность результатов анализов могут неверно подобранный метод диагностики и несоблюдение пациенткой правил подготовки к исследованию.
В том случае если женщина перед анализами:
- не отказалась от приема антибиотиков за 7-14 дней;
- имела половой контакт за 1 день;
- злоупотребляла спиртными напитками и курением;
- проводила спринцевания накануне;
- подмылась.
В этом случае высока вероятность получить неверные результаты, которые могут сказаться на правильной поставке диагноза и назначении лечения. Поэтому необходимо ответственно подходить к сдаче анализов.
Лечение стрептококка агалактии
Эффективный лечебный курс при выявлении стрептококка в гинекологии осуществляется с помощью антибиотиков пенициллинового ряда. Кроме того, он должен также включать в себя медикаментозные препараты различных сфер влияния.
| Наименование | Характеристика | Способ применения |
| Левофлоксацин | Раствор для инъекций, оказывающий противомикробное воздействие | Вводится внутривенно при помощи капельницы по 250–750 мг в сутки в зависимости от тяжести состояния |
| Джозамицин | Антибиотик макролидного характера, оказывает бактерицидное действие | Средняя суточная дозировка для взрослого – 2 гр, которые разводятся на 3 введения. Длительность приёма препарата назначается врачом и обычно не превышает 10 дней |
| Гексикон | Вагинальные свечи, оказывающие антисептический и дезинфицирующий эффект. Используются для профилактики и лечения инфекций, передающихся половым путём | В лечебных целях на протяжении недели 2 раза в день препарат вводится во влагалище. Для профилактики следует вводить свечу в течение 2 часов после интимной близости |
| Стрептококковые бактериофаги | Иммунобиологическое средство, способствующее разрушению вредоносного микроорганизма | За час до приёма пищи. Не рекомендуется совмещать приём с другими лекарственными препаратами |
| Лизобакт | Иммуностимулятор, усиливает действие антибиотиков | По 2 таблетки рассасывать 3 раза в день |
| Линекс | Пробиотическое средство, нормализует микрофлору кишечника, снижает негативное воздействие антибиотиков | Взрослым рекомендуется принимать в процессе лечения по 2 капсулы 3 раза в день |
| Бифиформ | Пробиотик, нормализует работу пищеварительного тракта | По 1 капсуле 2 раза в сутки на протяжении всего лечебного курса |
| Атоксил | Препарат, способствующий качественному выведению из организма токсичных веществ | Содержимое 1 пакета растворить в 100 мг воды и принимать за час до еды |
Лечить стрептококк агалактия необходимо под регулярным врачебным присмотром, выполняя все рекомендации.
Кроме лекарственных препаратов, необходимо включать в ежедневный рацион потребление витамина С. В случае выявления аллергической реакции на антибиотики пенициллинового ряда следует использовать в лечебной терапии макролиды.
При обнаружении в горле налёта, свидетельствующего о наличии стрептококковой ангины, запрещено осуществлять самостоятельную чистку – это приведёт к усугублению заболевания.
Стрептококки в мазке у женщин: стоит ли волноваться и опасно ли это?
Микрофлора женского влагалища состоит более чем из 100 видов разнообразных бактерий и микроорганизмов. Присутствие полезных и патогенных клеток обусловливается тем, что подобным образом организм пытается выработать иммунитет.
Благодаря иммунной системе полезные микроорганизмы контролируют патогенную флору, понижая численность вредных микроорганизмов. Механизм защиты женского влагалища и внутренних половых органов работает самостоятельно. Для поддержания его функционирования не нужно принимать дополнительные препараты, пользоваться свечами и т.д. Залог здоровой микрофлоры – это ведение здорового образа жизни и соблюдение правил гигиены.
Норма стрептококков в женском влагалище
В профилактических целях каждая женщина должна раз в полгода сдавать анализ на микрофлору. Результат покажет, из чего состоит слизистая и выделения.
Если в мазке обнаружили стрептококки, не стоит сразу паниковать. Дело в том, что в норме у каждой женщины во влагалище присутствуют стрептококки, стафилококки, энтерококки и т.д. Это не считается патологией при условии, что 95% содержимого мазка – это палочки Додерлейна (полезные лактобактерии), а только 5% – условно-патогенная микрофлора (стрептококки, грибки рода Кандида и т.д.).
Чтобы не переживать понапрасну, лучше поинтересоваться у врача, что означает присутствие стрептококков и требует ли данная проблема терапии. Как правило, гинеколог всегда успокаивает пациентку и говорит, что в этом нет ничего страшного.
Нужно лишь регулярно проходить осмотр и сдавать все необходимые анализы. У каждой здоровой женщины в мазке присутствуют стрептококки в малом количестве. Это нужно знать и не бояться задавать вопросы врачу.
Причины резкого увеличения количества стрептококков в мазке
Бывает и так, что мазке обнаруживает чрезмерное количество стрептококков, которое говорит о наличии воспалительного процесса. Это может происходить по разным причинам. Наиболее частыми предпосылками к росту стрептококков являются следующие факторы:
- наличие болезней, передающихся половым путем;
- снижение иммунитета вследствие дополнительных заболеваний;
- постоянные стрессы;
- депрессивные состояния;
- нарушенный режим сна;
- несбалансированный рацион питания;
- чрезмерная усталость и т.д.
Точную причину данной проблемы может выяснить только врач. Однако женщина, в мазке которой оказалось чрезмерное количество патогенной флоры, должна нормализовать свой образ жизни и следить за своей половой жизнью.
Нельзя часто менять партнеров. Если человек еще недостаточно знаком, то обязательно использовать барьерный метод контрацепции – презерватив.
Это знают практически все, однако, многие предпочитают игнорировать такие рекомендации. Из-за этого возникает множество проблем с женским здоровьем.
Симптомы, после которых нужно обращаться к гинекологу
Половые заболевания имеют схожие проявления. Однако женщина сразу понимает, что это не является нормой. Если наблюдается зуд, жжение или странные выделения из половых органов, это может говорить о том, что уровень стрептококков повысился. Понять это наверняка нельзя, потому что для уточнения диагноза нужно сдать анализ. Результаты будут даны лабораторией, и только после этого можно утверждать, какая именно патология присутствует в женском организме.
Также могут отмечаться боли в нижней части живота, обильные месячные или же наоборот долгое отсутствие менструации. На начальном этапе беременности стрептококки могут спровоцировать самопроизвольный выкидыш в форме менструации, о котором женщина даже не догадывается.
В любом случае это не является нормальным физиологическим состоянием, поэтому при обнаружении первых симптомов нужно немедленно идти на прием к гинекологу.
Лечение стрептококковой инфекции
Терапия требуется только в тех случаях, когда стрептококки превышают допустимую норму. Следует также учесть, что речь идет не о лечении от стрептококков, а об избавлении от факторов, которые спровоцировали рост этих бактерий. Чаще всего этими факторами являются заболевания, передающиеся половым путем. Например, хламидиоз, сифилис, гонорея, уреаплазмоз и т.д.
В зависимости от патологии доктор назначает лечение антибиотиками. После антибактериальной терапии в обязательном порядке нужно восстановить нормальную микрофлору. Для этого могут назначаться препараты, которые содержат в своем составе лактобактерии. Они выпускаются в форме вагинальных свечей и таблеток. Также могут назначаться спринцевания, чтобы вымыть патогенную микрофлору из влагалища.
Несвоевременно начатое лечение может стать причиной воспалительных процессов, образования кист и даже бесплодия. Поэтому не стоит медлить с визитом к гинекологу, если появились тревожные симптомы.
Лучше перестраховаться и лишний раз пройти обследование, чем потом страдать из-за невозможности зачать ребенка. Доктор проведет все необходимые манипуляции, чтобы узнать, какая патология спровоцировала появление конкретных признаков. Вовремя начатое лечение – гарантия здоровых детей в будущем и отсутствия проблем с половой жизнью.
Повышенный уровень бактерий при беременности
Вынашивание ребенка – ответственный период. Любые сбои в организме могут оказаться фатальными для плода. Именно поэтому повышение допустимого уровня стрептококков в мазке на микрофлору при беременности может плохо сказаться на состоянии ребенка. В этой ситуации женщине назначают пройти ряд дополнительных анализов.
Если выявляется половая инфекция или воспалительный процесс, то проводят щадящую терапию, которая не угрожает жизни будущего малыша. Ребенок защищен от инфекций плацентой, поэтому к кардинальным мерам, например, лечению антибиотиками пенициллиновой группы, можно и не прибегать в период вынашивания плода.
Также может быть такая ситуация, когда повышенные стрептококки являются нормальной реакцией организма на развитие в нем живого существа. Известно, что в период беременности иммунная система дает сбой. Это отражается, прежде всего, на состоянии женских половых органов. В это время развиваются кандидозы, бактериальные вагинозы и т.д. специального лечения такие патологические состояния не требуют. Достаточно того, чтобы женщина следила за рационом питания во время беременности, не подвергалась психологическим и эмоциональным стрессам.
После рождения малыша все показатели постепенно приходят в норму. Однако нужно постоянно находиться под присмотром гинеколога, который вел женщину в период беременности. Врач может назначить препараты, которые помогают восстановить нормальную микрофлору после рождения ребенка. В течение нескольких недель после родов уровень стрептококков понижается, неприятные симптомы исчезают, и новоиспеченная мама начинает жить привычной здоровой жизнью.
medickon.com
Стрептококковая инфекция при беременности
Развитие инфекции при беременности происходит вследствие ослабления иммунной системы и чаще всего диагностируется на 34–37 неделе, поскольку в этот период количество стрептококков на слизистых достигает максимального количества.
Выявление бактерии в мазке из влагалища у женщин во время вынашивания ребёнка нередко указывает на наличие цистита и уретрита.
Выделяется ряд факторов, свидетельствующих о необходимости более тщательного наблюдения за прохождением беременности:
- возраст будущей мамы меньше 20 лет;
- у ранее рождённых детей была выявлена бактерия;
- имеется большая вероятность преждевременных родов;
- в анализе мочи выявлено наличие стрептококков группы В.
Часто действие бактерии вызывает послеродовой эндометрит.
Влияние стрептококка на плод, ребенка
Стрептококк при беременности опасен для зародыша и плода, а затем и для новорожденного. Он ожжет заражаться еще внутриутробно, либо в период родов, что бывает гораздо чаще. Нередко признаки инфекции возникают не сразу, и это во многом зависит от того типа возбудителя, которым инфицировался кроха при рождении. Есть два разных типа инфекции, провоцируемой стрептококком группы В.
- с ранним началом инфекции, для которого самыми ведущими признаками будет выраженная лихорадка, дыхательные расстройства и постоянное угнетенное состояние младенца на протяжении первой недели жизни. Обычно все признаки начинают проявляться уже в первые сутки. Такое раннее начало стрептококкового заражения зачастую приводит к поражениям легких с образованием пневмонии, а также менингиту и септическим осложнениям.
У половины из новорожденных инфекция имеет раннее начало и неблагоприятные прогнозы.
- позднее начало болезни, при котором признаки могут быть специфическими. К ним относят наличие кашля с заложенностью носа и нарушением сосания груди, постоянная высокая лихорадка и выраженная сонливость, развитие судорог. Признаки могут возникать в период от 1 недели до 3 месяцев с момента родов. Нередко подобный тип инфекции приводит у детей к септическим осложнениям и менингиту.
Около 5% детей имеют летальные осложнения данной инфекции, среди недоношенных этот процент выше. Если ребенок выздоравливает, то перенесенная инфекция, вызванная гемолитическими стрептококками типа В, может формировать резидуальные (остаточные) явления в виде церебральных параличей, приводящих к проблемам развития головного мозга, что приводит к нарушениям осанки, двигательных функций и тонуса мышц. Также возможны проблемы с развитием органа слуха и внешние дефекты, нарушения обучения.
Возможные осложнения
Активная деятельность бактерии приводит к выделению в организм большого количества токсичных веществ.
| Токсин | Воздействие на работу организма |
| Лейкоцидин | Ухудшает работу иммунной системы, уничтожая её клеточную структуру |
| Стрептолизин | Разрушает тканевые покровы организма, а также целостность кровяных и сердечных клеток |
| Некротоксин и летальный токсин | Приводят к некрозу тканей |
| Протеиназа, стрептокиназа, амилаза и гиалуронидаза | Способствуют лучшему распространению стрептококка по человеческому организму и пожиранию здоровых тканей |
Распространение вышеперечисленных веществ осуществляется через кровь. Иммунная система начинает выработку антител для борьбы с вредоносными бактериями, которые, в свою очередь, поражают и здоровые клетки, в результате чего развиваются заболевания аутоиммунного характера.
При отсутствии своевременного лечения у будущих мам может развиться ряд осложнений:
- хориоамнионит, характеризующийся воспалением оболочки и жидкости, которые окутывают эмбрион;
- аллергические заболевания в тяжёлой форме;
- болезни сердца и сосудов;
- гнойный отит;
- самопроизвольный аборт;
- инфекционные заболевания мочевыделительных путей;
- эндокардит.
Профилактика
Существует ряд эффективных профилактических мер, снижающих риск возникновения стрептококка агалактия:
- регулярное соблюдение правил личной гигиены и чистоты жилого помещения;
- сбалансированный ежедневный рацион, употребление продуктов, богатых витаминами и микроэлементами;
- отказ от вредных привычек;
- избегание сильного переохлаждения организма;
- изоляция больных на время прохождения лечения и дезинфекция помещения, в котором находился инфицированный человек;
- регулярные занятия спортом;
- отказ от посещения салонов и клиник с неудовлетворительным уровнем соблюдения санитарных норм.
Чтобы не ослаблять свой организм, откажитесь от вредных привычек
Нельзя дать однозначный ответ на вопрос, откуда берётся эта бактерия — она присутствует в человеческом организме в небольшом объеме на протяжении всей жизни. Значительный рост количества этого микроорганизма представляет большую опасность для здоровья человека, поскольку способствует разрушению эритроцитов.
Своевременное выявление стрептококка агалактия и подбор наиболее эффективного лечения поможет избежать развития осложнений, а при беременности снизит риск внутриутробного инфицирования.